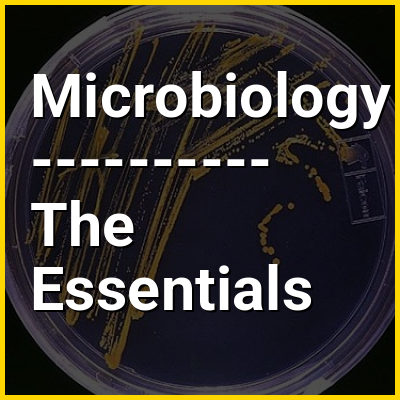

Bacteria are ubiquitous, mostly free-living organisms often consisting of one biological cell. They constitute a large domain of prokaryotic microorganisms. Typically a few micrometres in length, bacteria were among the first life forms to appear on Earth, and are present in most of its habitats. Bacteria inhabit the air, soil, water, acidic hot springs, radioactive waste, and the deep biosphere of Earth's crust. Bacteria play a vital role in many stages of the nutrient cycle by recycling nutrients and the fixation of nitrogen from the atmosphere. The nutrient cycle includes the decomposition of dead bodies; bacteria are responsible for the putrefaction stage in this process. In the biological communities surrounding hydrothermal vents and cold seeps, extremophile bacteria provide the nutrients needed to sustain life by converting dissolved compounds, such as hydrogen sulphide and methane, to energy. Bacteria also live in mutualistic, commensal and parasitic relationships with plants and animals. Most bacteria have not been characterised and there are many species that cannot be grown in the laboratory. The study of bacteria is known as bacteriology, a branch of microbiology.
Like all animals, humans carry vast numbers (approximately 10 to 10) of bacteria. Most are in the gut, though there are many on the skin. Most of the bacteria in and on the body are harmless or rendered so by the protective effects of the immune system, and many are beneficial, particularly the ones in the gut. However, several species of bacteria are pathogenic and cause infectious diseases, including cholera, syphilis, anthrax, leprosy, tuberculosis, tetanus and bubonic plague. The most common fatal bacterial diseases are respiratory infections. Antibiotics are used to treat bacterial infections and are also used in farming, making antibiotic resistance a growing problem. Bacteria are important in sewage treatment and the breakdown of oil spills, the production of cheese and yogurt through fermentation, the recovery of gold, palladium, copper and other metals in the mining sector (biomining, bioleaching), as well as in biotechnology, and the manufacture of antibiotics and other chemicals.